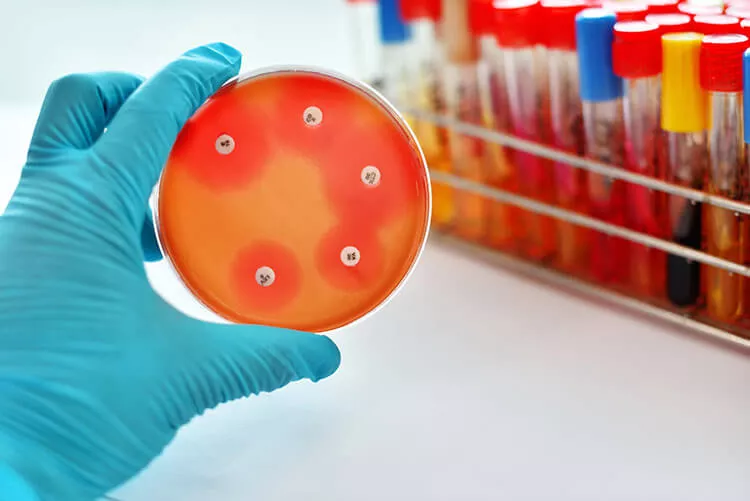
Ilustrační obrázek

Reportáže a rozhovory z odborných kongresů
Jakou roli hrají bakterie u pacientů s hidradenitis suppurativa? Které skupiny antibiotik mají evidence-based data pro léčbu tohoto onemocnění? A jak velký problém představuje antibiotická rezistence? Zejména o těchto tématech diskutoval na kongresu EADV 2022 Dr. Thrasyvoulos Tzellos, MD, MSc, PhD, z Nordlandssykehuset Bodø v Norsku.
Na úvod T. Tzellos připomněl, že hidradenitis suppurativa (HS) představuje chronické kožní zánětlivé onemocnění, s vyšší mírou zánětu než v případě psoriázy, jehož propagaci ovlivňuje životní styl a genetická predispozice. „Víme, že bakteriální infekce tvoří pouze malou část celého patologického procesu,“ poznamenal s tím, že mnoho studií se snažilo posoudit a charakterizovat bakteriální mikrobiom v celém spektru HS lézí. Ukázalo se, že s klinickou progresí lézí a závažností onemocnění se zvyšovala zátěž obligatorně, a fakultativně anaerobními mikroorganismy. Přítomnost kožních komenzálů a anaerobů byla spojena s HS ve stadiu I dle Hurleyho, ve stadiích II a III se pak častěji vyskytovaly anaeroby, anaerobní aktinomycety a bakterie skupiny Streptococcus milleri. „Dosud však nemáme žádný důkaz, že cílená antibiotická terapie podle Hurleyho stadií je racionálním přístupem a že můžeme kultivaci použít k informovanému výběru antibiotik u hidradenitis suppurativa“ konstatoval T. Tzellos a dodal: „Antibiotika v léčbě těchto pacientů nepochybně hrají svou roli – s největší pravděpodobností však ne proto, že mají antibakteriální účinek, ale proto, že některá z nich působí velmi dobře protizánětlivě.“
Pokud se týká obecně antimikrobiální rezistence, upozornil na data European Medicines Agency, ze kterých mimo jiné vyplývá, že existuje stále větší propast mezi infekcemi způsobenými rezistentními bakteriemi a vývojem nových antibiotik. Každým rokem přitom v EU zemře v důsledku bakteriálních infekcí, odolných vůči mnoha lékům, nejméně 25 000 pacientů. „Výskyt rezistentních bakteriálních kmenů tak může snížit účinnost antibiotik i u hidradenitis suppurativa, zvýšit náchylnost k závažným infekčním onemocněním a vést k rozvoji komorbidit asociovaných se změněnou mikrobiální flórou,“ naznačil T. Tzellos. V této souvislosti se zmínil o recentní studii, která prokázala, že širší použití antibiotik u jedinců s HS může být spojeno se vznikem klostridiové infekce a zvýšeným rizikem mortality (Sanghvi AP et al., Br J Dermatol 2022). Mezi rizikové faktory patřily vyšší třída antibiotik, hospitalizace a pokročilý věk nemocných.
Dále T. Tzellos prezentoval několik prací týkajících se bakteriální rezistence u HS, přičemž některé z nich poskytly protichůdné důkazy. Retrospektivní studie zahrnující vzorky lézí od 113 pacientů (Hessam S et al., Skin Pharmacol Physiol 2016) poukázala na fakt, že izolované kmeny bakterií (nejčastěji koaguláza negativní stafylokoky a Staphylococcus aureus) byly primárně rezistentní na penicilin G, erytromycin, klindamycin a ampicilin. Klindamycin byl shledán rezistentním v 55 % případů, tetracyklin v 33 % a chinolony přibližně v 10 %. Výsledky této studie by však měly být interpretovány s opatrností, a to z důvodu krátké kultivační inkubační doby, což potenciálně narušuje izolaci velké části anaerobní flóry. Z práce Alexandera H. Fischera a spolupracovníků, publikované roku 2017 (Fischer AH et al., J Am Acad Dermatol 2017), zase vyplynulo, že jedinci s HS léčení topickým klindamycinem, ciprofloxacinem nebo trimetoprimem/sulfametoxazolem měli významně vyšší pravděpodobnost, že budou odolávat antibiotické terapii, v porovnání s těmi, kteří tuto léčbu neužívali – konkrétně 63 % vs. 17 %, respektive 100 % vs. 10 %, respektive 88 % vs. 0 %. U tetracyklinů nebo perorálního klindamycinu ale žádná významná antimikrobiální rezistence pozorována nebyla. Studie z italských pracovišť (Bettoli V et al., J Eur Acad Dermatol Venereol 2019) pak naznačila, že léčba klindamycinem, rifampicinem, penicilinem, ciprofloxacinem, tetracykliny a erytromycinem byla spojena s velmi vysokou mírou rezistence, pohybující se od cca 65 % do 90 %. „Naopak nejnižší byla při podávání vankomycinu, linezolidu nebo trimetoprimu/sulfametoxazolu, což je v rozporu se závěry předchozí studie,“ komentoval T. Tzellos a dodal, že další protichůdné údaje poskytla práce Christine B. Ardon a spolupracovníků, zveřejněná roku 2019 (Ardon CB et al., J Eur Acad Dermatol Venereol 2019). Ta totiž zjistila, že vysoké procento kmenů druhu Staphylococcus epidermidis bylo citlivých na rifampicin a také na tetracyklin. A konečně nejnověji publikovaná studie (Barmatz S et al., Dermatology 2022) se zbývala posouzením bakteriologie aktivních HS lézí u pacientů léčených, či neléčených antibiotiky v komunitním prostředí před odesláním na specializované pracoviště.
Ukázalo se, že nejčastěji byly předepisovány amoxicilin/klavulanát, doxycyklin/minocyklin, klindamycin a cefalexin. Testování citlivosti pro celou kohortu odhalilo 100% bakteriální senzitivitu vůči ciprofloxacinu, jak grampozitivní, tak gramnegativní bakterie pak byly vysoce senzitivní na trimetoprim/sulfametoxazol. „Kdybychom tedy měli z dostupných údajů vyvodit nějaké závěry, mohli bychom jednoduše shrnout, že antibiotika se při léčbě hidradenitis suppurativa používají a že vzrostla míra bakteriální rezistence. Zkusme se ale podívat na to, jak bychom mohli s antibiotickou terapií nakládat, abychom zvýšili její účinnost či účelnost,“ poznamenal T. Tzellos s odkazem na doporučení HS ALLIANCE working group (Zouboulis CC et al., J Eur Acad Dermatol Venereol 2019). Z nich mimo jiné vyplývá následující:
„Kdybychom se obecně zamysleli nad některými klíčovými body, které souvisejí s indikací antibiotik u HS, přijdeme na to, že pro užití jiných léků, než zmiňují guidelines, neexistují evidence-based data. Dále bychom zjistili, že je k dispozici jen velmi málo střednědobých či dlouhodobých údajů a studií s velkými soubory nemocných, že bychom se měli vyvarovat poddávkování a že musíme antibiotickou terapii včas ukončit, pokud není efektivní,“ zdůraznil T. Tzellos s tím, že velmi často dochází k recidivám HS, proto je nutná udržovací léčba. „Po dobu maximálně 12 týdnů by se mělo používat pouze jedno antibiotikum ze stejné třídy – opravdu nedává žádný smysl znovu a znovu switchovat mezi léky ze stejné třídy,“ dodal s tím, že v případě recidivy lze podat stejný antibiotický přípravek, pokud byl dříve účinný. Pro dlouhodobou terapii mírné až středně těžké HS se ve světle antibiotické rezistence zdá být vhodnou alternativou topický resorcinol 15 %.
Závěrem se T. Tzellos zmínil o nedávno publikované celoevropské prospektivní, kohortové studii z reálné klinické praxe (Van Straalen KR et al., J Am Acad Dermatol 2021), která zjistila, že u pacientů s HS, léčených perorálními tetracykliny nebo kombinací klindamycinu s rifampicinem, nebyly zjištěny žádné významné rozdíly v účinnosti, bez ohledu na závažnost onemocnění. To by znamenalo, že tetracykliny by se mohly stát metodou první volby i u středně těžké až těžké HS. Po selhání systémové antibiotické terapie lze pak jedincům (starším 12 let) s aktivní středně těžkou až těžkou HS indikovat biologika. „Během biologické léčby je jistě možné pokračovat v podávání antibiotik a zároveň je doporučeno každodenní antiseptické oplachování lézí,“ uzavřel přednášející.
(red)

Reportáže a rozhovory z odborných kongresů
Opouštíte prostředí společnosti Pfizer, spol. s r. o.
Společnost Pfizer, spol. s r. o., neručí za obsah stránek, které hodláte navštívit.
Přejete si pokračovat?